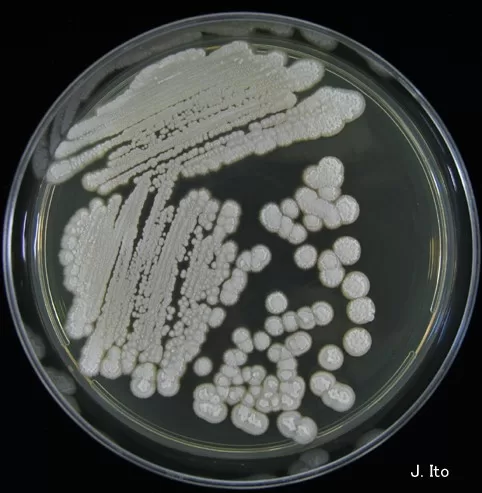

*Trichosporon asahii* has gained significance as a leading cause of nosocomial infections, particularly affecting immunocompromised individuals. This opportunistic fungus poses a substantial threat due to its ability to transmit within hospital environments, leading to alarming fungal transmission events. Recent studies utilizing microsatellite typing have shed light on the genetic diversity of *T. asahii*, highlighting its varied genotypic landscape across different isolates. Such insights are crucial for epidemiological surveillance, as they can help in tracking infection outbreaks and understanding transmission dynamics. By enhancing our knowledge of *Trichosporon asahii*, we can better prepare healthcare systems to combat this emerging fungal infection.
The fungus known as *T. asahii* represents an increasing concern in medical mycology as a key agent of hospital-acquired infections. Predominantly problematic for patients with weakened immune systems, this pathogen thrives in healthcare settings, highlighting the risks associated with nosocomial outbreaks. By employing advanced techniques such as microsatellite analysis, researchers are uncovering the intricacies of its genetic variation and transmission patterns. With a focus on enhancing epidemiological tracking and understanding the complexities of fungal behavior, the insights gathered from *T. asahii* studies are vital for developing effective control measures against this persistent health threat. Understanding the scope and implications of this organism is essential for safeguarding vulnerable populations from its potentially severe impacts.
Understanding the Role of Trichosporon asahii in Nosocomial Infections
*Trichosporon asahii* is increasingly recognized as a significant cause of nosocomial infections, particularly among immunocompromised individuals. These infections can pose severe risks, leading to increased morbidity and mortality rates. Nosocomial infections, often acquired in healthcare settings, require special attention due to their potential for outbreaks within susceptible populations. As healthcare systems become more reliant on invasive techniques and immunosuppressive therapies, the threat from opportunistic pathogens like *T. asahii* grows, making understanding its epidemiology critical.
The emergence of *T. asahii* as a human pathogen has been tied to its ability to thrive in clinical environments, making it a subject of focused epidemiological surveillance. By examining cases of *T. asahii*, we can identify transmission events that occur within hospitals, implicating the organism in healthcare-associated outbreaks. The application of advanced typing methods, such as microsatellite typing, not only illuminates genetic diversity among the isolates but also enhances our understanding of transmission dynamics, thereby informing better control measures.
Frequently Asked Questions
What is Trichosporon asahii and why is it a concern for nosocomial infections?
*Trichosporon asahii* is a fungal pathogen that poses significant risks for nosocomial infections, especially in immunocompromised patients. Its ability to transmit in healthcare settings highlights the importance of understanding its epidemiology and genetic diversity.
How does microsatellite typing contribute to understanding Trichosporon asahii transmission dynamics?
Microsatellite typing allows for the detailed genetic profiling of *Trichosporon asahii* isolates, enabling researchers to track nosocomial transmission events and assess the genetic diversity among strains effectively.
What are the implications of genetic diversity of Trichosporon asahii in nosocomial settings?
The genetic diversity of *Trichosporon asahii* impacts its transmission dynamics in nosocomial settings. Higher diversity can indicate multiple transmission events, complicating outbreak management and necessitating thorough epidemiological surveillance.
How effective is microsatellite typing in identifying Trichosporon asahii transmission events?
Microsatellite typing has shown high discriminatory power in identifying transmission events of *Trichosporon asahii*, as evidenced by its ability to differentiate among up to 71 genotypes in clinical isolates, making it a valuable tool for outbreak tracking.
What role does epidemiological surveillance play in controlling Trichosporon asahii infections?
Epidemiological surveillance is crucial in controlling *Trichosporon asahii* infections as it helps in early detection of transmission events, informing public health interventions aimed at reducing the incidence of nosocomial infections.
Can microsatellite typing be used globally for Trichosporon asahii surveillance?
Yes, microsatellite typing can be adapted for global use in *Trichosporon asahii* surveillance. Its high reproducibility and specificity make it a vital tool for tracking strains in diverse healthcare settings across different geographical regions.
What are the benefits of using long-read nanopore sequencing for Trichosporon asahii research?
Long-read nanopore sequencing facilitates comprehensive genome analysis of *Trichosporon asahii*, helping to identify complex genetic regions and numerous microsatellite loci, which enhances understanding of its genetic diversity and transmission potential.
What evidence points to ongoing nosocomial transmission of Trichosporon asahii in South America?
The identification of multiple clusters of *Trichosporon asahii* isolates from the same hospitals in Brazil, some dating back to 2001, provides strong evidence of persistent nosocomial transmission in South America.
How does Trichosporon asahii transmission affect public health measures?
Understanding *Trichosporon asahii* transmission is essential for developing effective public health measures. By identifying transmission patterns, healthcare facilities can implement targeted control interventions to mitigate the risks associated with this emerging fungal pathogen.
What are the key findings regarding Trichosporon asahii from recent studies?
Recent studies highlight the genetic diversity of *Trichosporon asahii*, the effectiveness of microsatellite typing in tracking transmission events, and the pressing need for enhanced epidemiological surveillance in healthcare systems to combat nosocomial infections.
| Key Point | Details |
|---|---|
| Emerging Pathogen | *Trichosporon asahii* is a significant cause of nosocomial infections, particularly in immunocompromised individuals. |
| Microsatellite Typing | A microsatellite typing tool was developed, using 6 markers, to investigate genetic diversity among *T. asahii* isolates. |
| Genetic Diversity | 111 clinical and environmental isolates exhibited high genetic variability with 71 distinct genotypes identified. |
| Transmission Events | Multiple nosocomial transmission clusters were identified in Brazilian hospitals, some spanning over a decade. |
| Public Health Implications | The findings highlight the need for continued surveillance and targeted interventions to control the spread of *T. asahii* in healthcare settings. |
Summary
Trichosporon asahii has emerged as a critical pathogen in nosocomial infections, highlighting the necessity for enhanced detection and epidemiological tracking methods. The developed microsatellite typing tool is instrumental in identifying genetic diversity and tracing transmission pathways in hospital settings across South America. Continuous surveillance and interventions are essential to mitigate the risks posed by this opportunistic fungal pathogen.
The content provided on this blog (e.g., symptom descriptions, health tips, or general advice) is for informational purposes only and is not a substitute for professional medical advice, diagnosis, or treatment. Always seek the guidance of your physician or other qualified healthcare provider with any questions you may have regarding a medical condition. Never disregard professional medical advice or delay seeking it because of something you have read on this website. If you believe you may have a medical emergency, call your doctor or emergency services immediately. Reliance on any information provided by this blog is solely at your own risk.